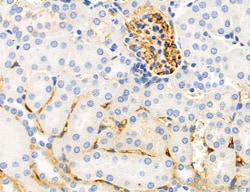
Invitrogen Phospho-MYL2 (Ser15) Polyclonal Antibody 100 &mu;L; Unconjugated:Antibodies,

missing translation for 'onlineSavingsMsg'
Learn More
Learn More
Invitrogen™ Phospho-MYL2 (Ser15) Polyclonal Antibody


Rabbit Polyclonal Antibody
Brand: Invitrogen™ PA5104265
This item is not returnable.
View return policy
Description
Antibody detects endogenous levels of MLC2 only when phosphorylated at Ser15.
Thus gene encodes the regulatory light chain associated with cardiac myosin beta heavy chain. Ca+ triggers the phosphorylation of regulatory light chain that in turn triggers contraction. Mutations in this gene are associated with mid-left ventricular chamber type hypertrophic cardiomyopathy.
Specifications
| Phospho-MYL2 (Ser15) | |
| Polyclonal | |
| Unconjugated | |
| MYL2 | |
| cardiac myosin light chain 2; cardiac myosin light chain-2; cardiac ventricular myosin light chain 2; CMH10; DKFZp779C0562; hypothetical protein LOC677750; Mlc2; MLC-2; mlc2b; MLC-2s/v; MLC2V; MLC-2v; myl2; myl2b; Mylpc; myosin light chain 2; myosin light chain 2, slow skeletal/ventricular muscle isoform; myosin light chain 2V; myosin light chain phosphatase; myosin light chain, phosphorylatable, cardiac ventricles; myosin light chain-2; myosin regulatory light chain 2, ventricular/cardiac muscle isoform; myosin regulatory light chain 2b; myosin regulatory light chain ventricular isoform; myosin, light chain 2, regulatory, cardiac, slow; myosin, light chain 2b, regulatory, cardiac, slow; myosin, light polypeptide 2, regulatory, cardiac, slow; myosin, light polypeptide 2b, regulatory, cardiac, slow; regulatory light chain of myosin; RLC of myosin; slow cardiac myosin regulatory light chain 2; ventricular myosin light chain 2; ventricular myosin regulatory light chain; zgc:136848 | |
| Rabbit | |
| Sequential chromatography | |
| RUO | |
| 17906, 363925, 4633 | |
| -20°C | |
| Liquid |
| Immunohistochemistry (Paraffin), Western Blot, Immunocytochemistry | |
| 1 mg/mL | |
| PBS with 50% glycerol and 0.02% sodium azide; pH 7.4 | |
| P08733, P10916, P51667 | |
| MYL2 | |
| A synthesized peptide derived from human MYL2(Accession P10916), corresponding to amino acid residues around phosphorylated Ser15. | |
| 100 μL | |
| Primary | |
| Human, Mouse, Rat | |
| Antibody | |
| IgG |
Product Content Correction
Your input is important to us. Please complete this form to provide feedback related to the content on this product.
Product Title
Spot an opportunity for improvement?Share a Content Correction